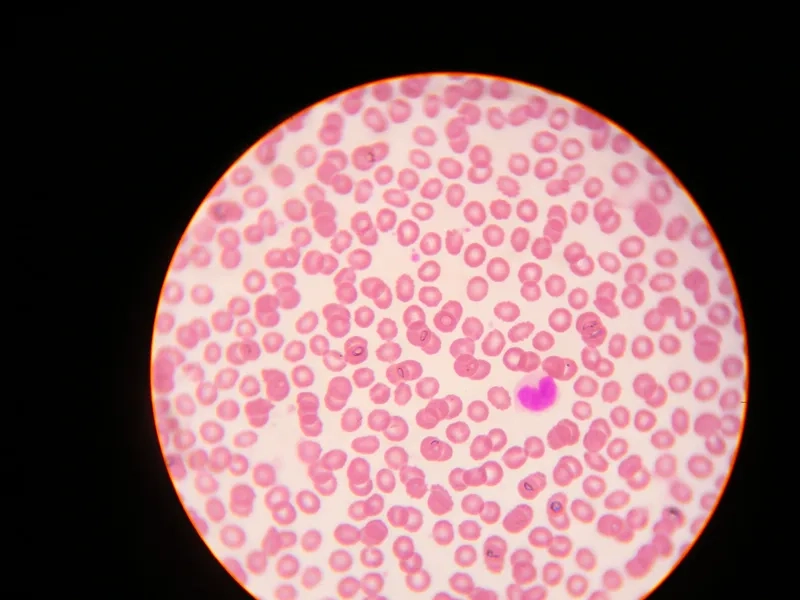
Các loại tế bào máu (hồng cầu, bạch cầu, tiểu cầu)
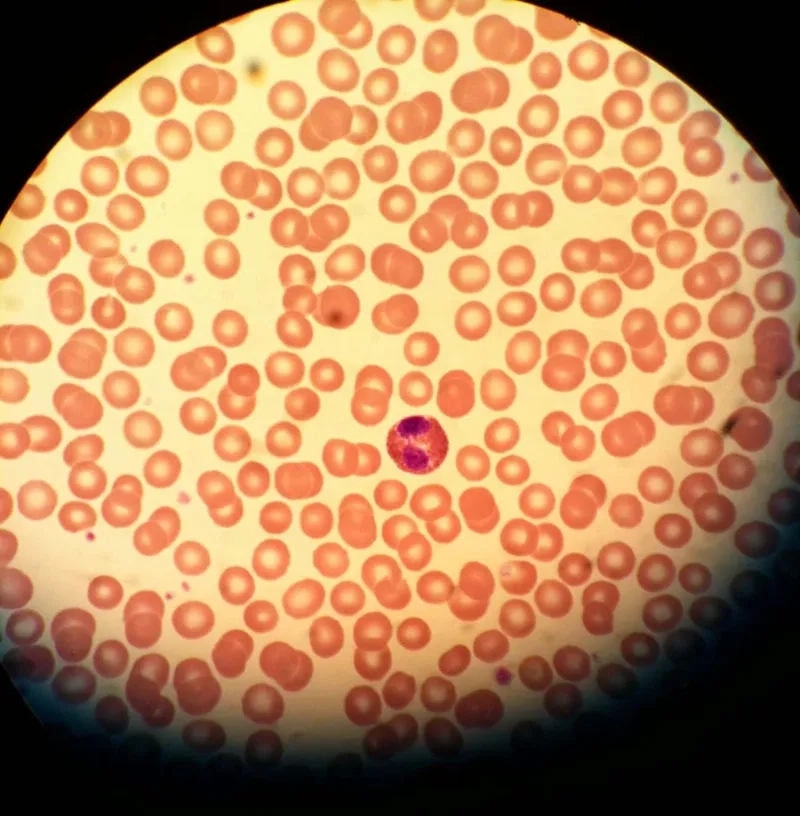
Cấu tạo tế bào máu với nhân và bào tương
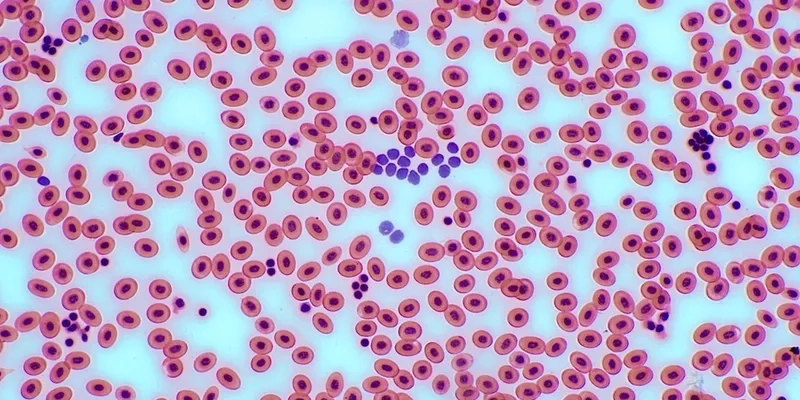
Hồng cầu dưới kính hiển vi hình đĩa lõm hai mặt
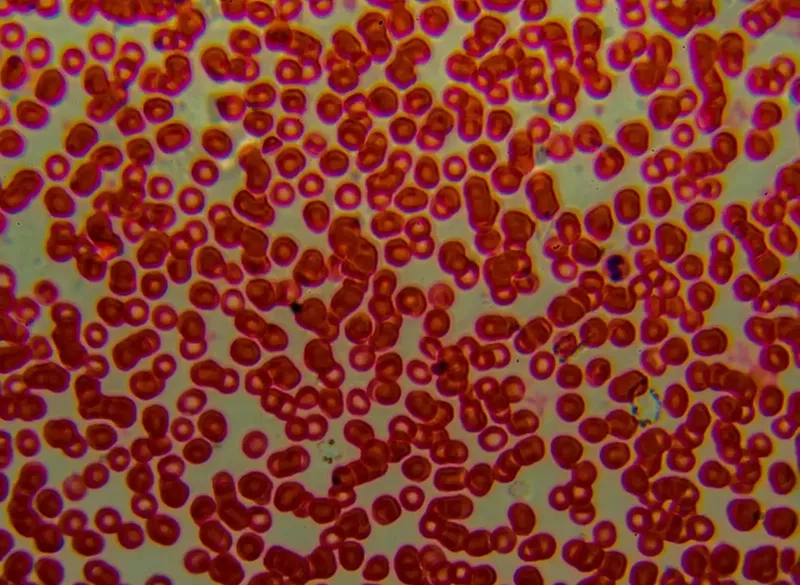
Bạch cầu dưới kính hiển vi lớn hơn hồng cầu
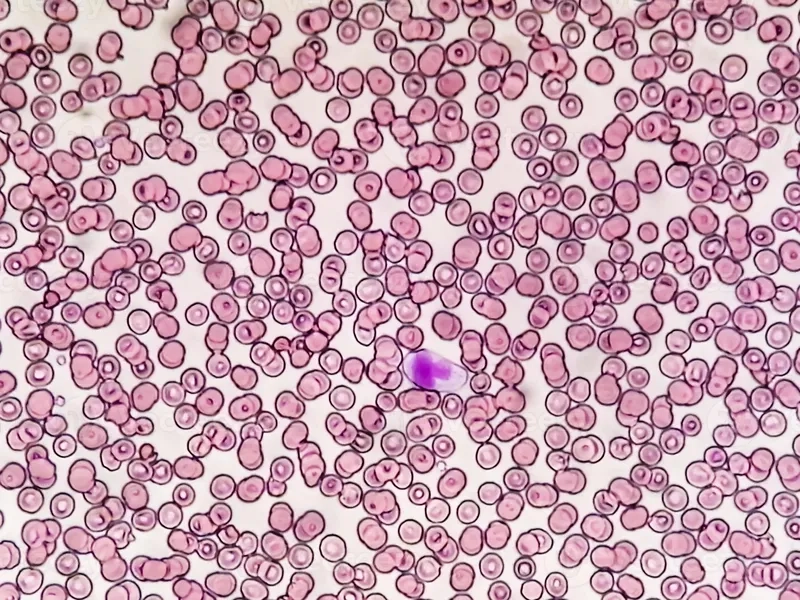
Tiêu bản máu ngoại vi được cố định và nhuộm
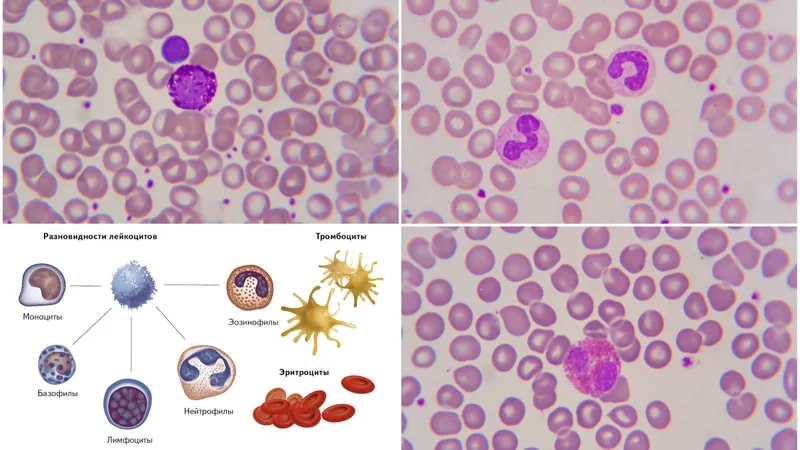
Phết máu ngoại vi để quan sát hình thái
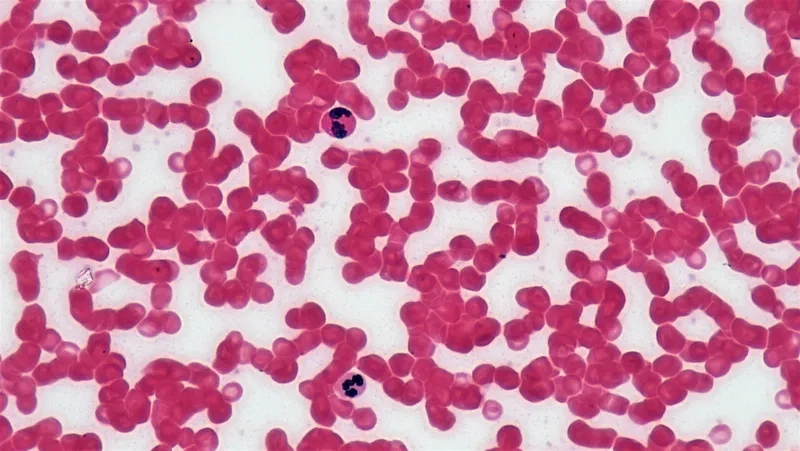
Tế bào máu bình thường khỏe mạnh

Tế bào máu dưới kính hiển vi là một trong những hình ảnh cơ bản và quan trọng nhất trong nghiên cứu sinh học và y học. Máu, thành phần thiết yếu của cơ thể, là một hệ thống phức tạp gồm nhiều loại tế bào khác nhau.
Cấu tạo và chức năng của tế bào máu
Cấu tạo tế bào máu bao gồm ba thành phần chính: hồng cầu dưới kính hiển vi, bạch cầu dưới kính hiển vi và tiểu cầu dưới kính hiển vi. Các loại tế bào máu này được quan sát rõ nét nhất trên tiêu bản máu ngoại vi đã được nhuộm Giemsa.

Mỗi loại tế bào có chức năng tế bào máu chuyên biệt: hồng cầu chịu trách nhiệm vận chuyển oxy, bạch cầu bảo vệ cơ thể khỏi tác nhân gây bệnh, còn tiểu cầu tham gia vào quá trình đông máu.
Khám phá hình ảnh tế bào máu dưới kính hiển vi
Khám phá những hình ảnh tế bào máu trong bộ sưu tập này sẽ giúp bạn phân biệt giữa tế bào máu bình thường với tế bào máu thiếu máu hay hình ảnh tế bào ung thư máu.

Tế bào máu dưới kính hiển vi là một thế giới vi mô đầy phức tạp, phản ánh chính xác tình trạng sức khỏe của cơ thể. Việc tìm hiểu cấu tạo và chức năng của tế bào máu là nền tảng của y học.